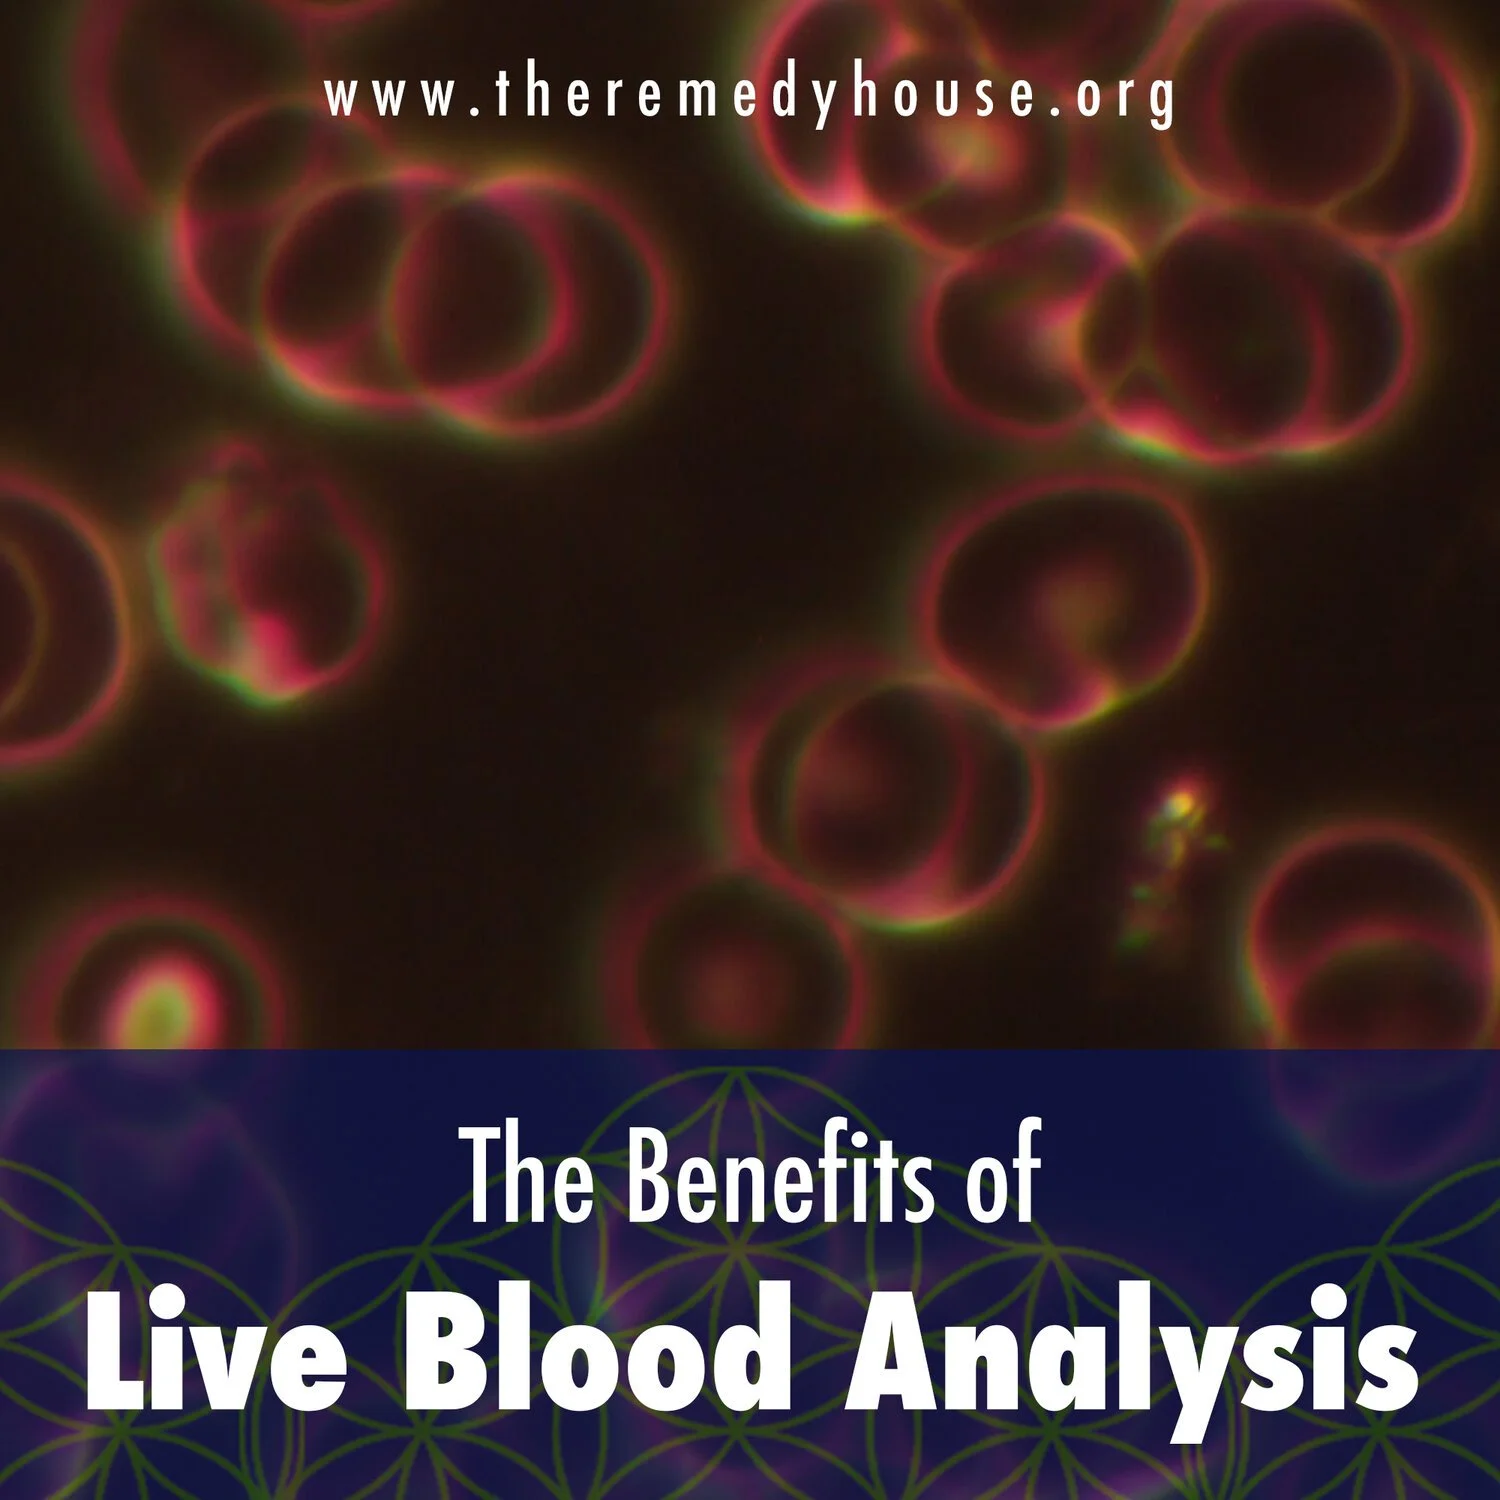

The Benefits of Live Blood Analysis
Live Blood Analysis
Live blood analysis – also known as nutritional microscopy or sometimes darkfield microscopy biological terrain assessment – is fundamentally the analysis of living blood under an extremely powerful microscope connected to a camera. The condition and quality of your red blood cells have a direct impact on your present and future health, with stress and disease appearing in the blood years before they manifest in the body. So what do your blood cells look like? We are not looking for patterns that lead to a ‘diagnosis’ in any shape or form, but are merely looking for imbalances in the pH levels in your blood.
Live blood testing enables us to see your blood exactly as it behaves inside your body, giving a clear picture of your health at a cellular level.
What does this consultation involve?
A few drops of capillary blood are obtained from your finger tip using a sterile lancet. This is then placed on a slide covered with a cover slip to protect it from the outside elements. Your blood is then examined immediately under a very high powered microscope (magnified 20,000 times) and the results captured on camera, enabling you to view your live blood – still interacting and moving around – on a video screen alongside a qualified nutritional microscopist. By analyzing how your blood picture relates to the level of health challenges experienced by you, any needs and/or deficiencies relating to your nutrition can be easily identified. A specific tailor-made healthy eating plan is then prescribed using food as medicine to restore your blood to a healthy condition by removing the excess acidity and toxins.
How does it work?
Once the extracted blood is placed under the microscope and relayed to a video monitor, you will be able to see live on the screen the quality of your red blood cells, the activity of your white blood cells, and whether there are bacteria, yeasts, molds or fungus present. Any uric acid, breast imbalances, parasites, vitamin deficiency, heavy metals, organ stress (liver, cholesterol, kidney, pancreatic, prostate, ovarian, breast) or imbalances associated with degenerative conditions will also be detected. In addition, you will receive an overall picture of how you have been living, eating and thinking over the past 120 days. By observing and monitoring metabolic function or dysfunction, live blood testing removes the guesswork from diet determination and the selection of appropriate foods, drinks and exercise.
blog written by:
Jodi Jenks ND
Jodi started her journey as a holistic healer over 27 years ago when she began to see her homeopathic doctor where she learned Essential Oil Therapies and she took Reiki training from two Reiki Masters back in the mid 1990's. She expanded her education in natural health at the Naturopathic Institute of Therapies and Education and in 2017 she became a board certified Naturopathic Doctor.